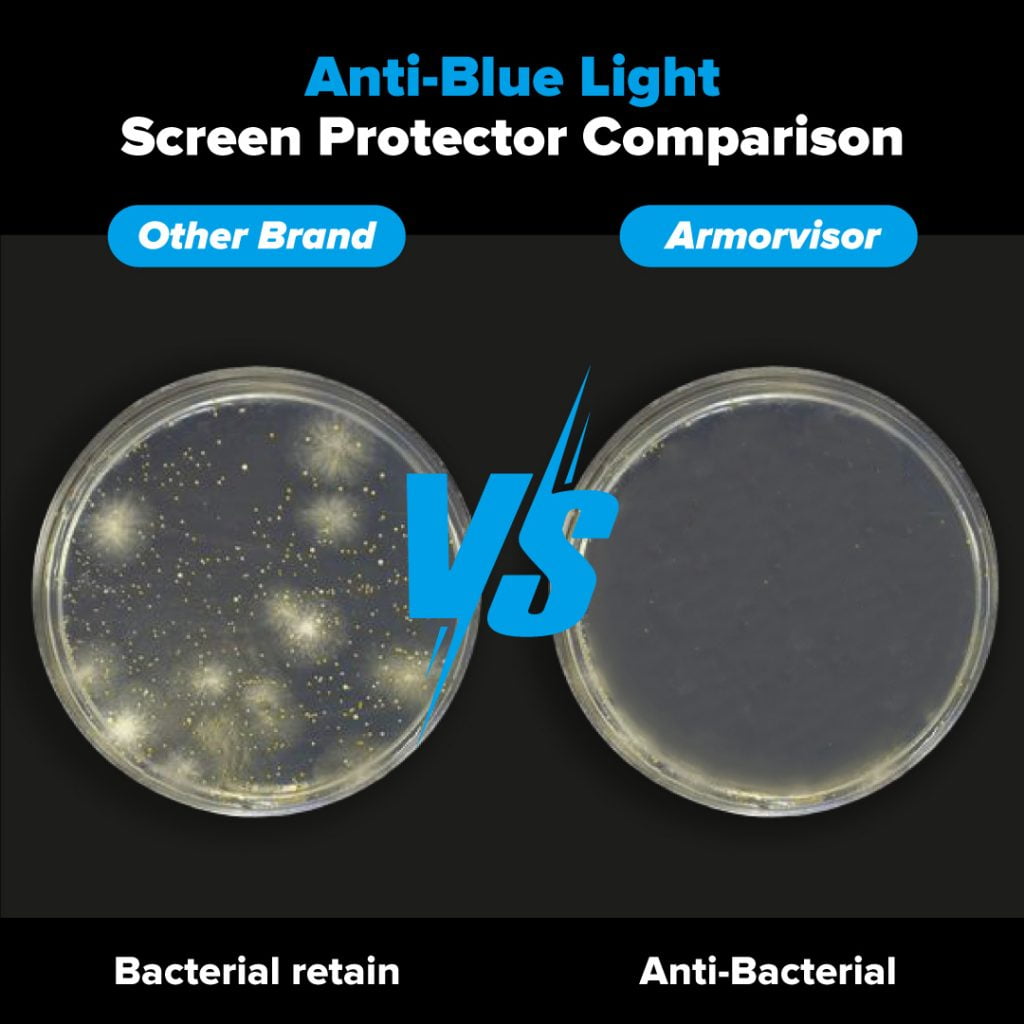

What is Blue Light?
Be educated on the harmful effects of Blue Light.

Blue light is light in the visible light spectrum known for its short wavelength and intensity.
It is naturally present in the sun, delivering our brain messages that we should be awake and aware throughout the day.
However, we also spend so much time watching digital gadgets, which might give our brain numerous confusing signals. For example, blue light overstimulates our eyes and hinders the generation of melatonin in our brain, which is a substance that helps us sleep healthily.
How is it Affecting Us?
Because we spend so much time on digital gadgets, we may experience theses symptoms as a result of the increased exposure to blue light.

Digital Eye Strain
Digital screen exposure and blue light contribute to digital eye strain, including: red itchy dry eyes, impaired vision, eye fatigue, neck discomfort, and headaches.

Sleep Disruption
Your normal sleep pattern is governed by the quantity of light you are exposed to, and since our eyes are continually exposed to blue light throughout the day, the body does not know when to prepare for sleep. Blue light inhibits the generation of the sleep hormone melatonin, reducing both the amount and quality of your sleep.

Skin Aging
Blue light may affect your skin since it penetrates the dermis over the whole area and may destroy collagen and elastin cells. Collagen strengthens the skin while elastin allows the skin to stretch and bounce back. The skin also has a lot of natural night time to heal, which might contribute to premature skin ageing if you’re not getting enough sleep.
The Real Anti-Blue Light Screen Protector
Efficiently blocks the most harmful spectrum of digital light.

Unlike any other anti-blue light screen protectors in the market mobile applications and activating ‘night mode,’ which gives you an orange or purple tint to your screen, Armorvisor achieves this without discolouring your screen by retaining the true colors of your screen.
With all that blue light absorbed before it can reach your eyes, you will suffer less pain using digital gadgets and enjoy a more peaceful night’s sleep at the conclusion of every action-packed day.
True Color | Less Eye Pain
Buy Now
Purple Tint Vs Clear & Effective
What makes the differences?
| Other Brands | Armorvisor | |
|---|---|---|
| Color | Purple/yellow tint, color distortion | True Color. Screen clarity remains 97%. |
| Glare | Blue light reflected, causing glare | Premium Anti-Glare |
| Coating Layer | Smooth coating you love from your average glass protectors. | Fused with Lotus FX coating giving you smooth with easy cleaning surface. |
| HELV Filtration | HEVL is not filtered | Filters High Energy Visible Light (HEVL) 380nm – 450nm at 100% |
| Anti-bacterial | Some may have anti-bacterial function | Formulated with Silver Ions which effectively kills 99% of harmful bacteria |
| Impact Protection | Glass breaks fairly easy. | 6X stronger Impact Protection than glass protectors. |
Choose Your Model